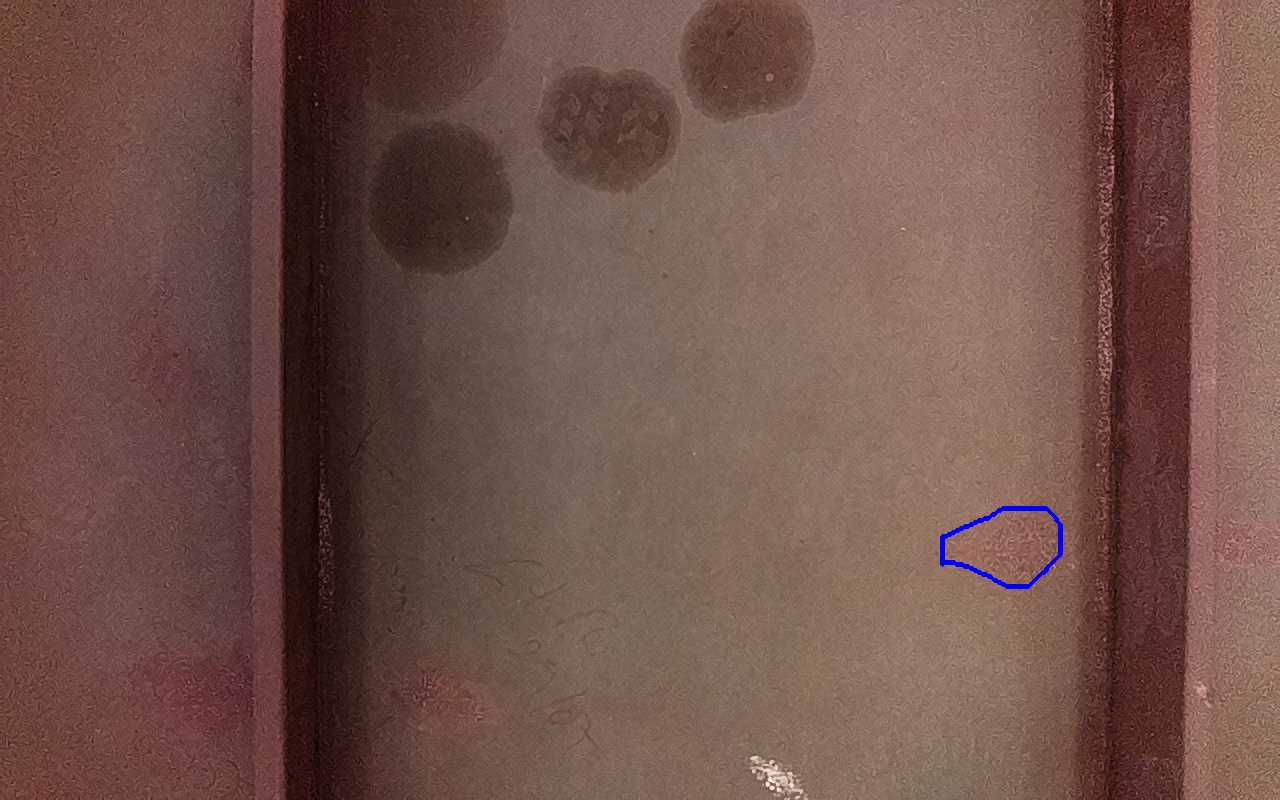

Proviene de:
IV-4
ID: 246747
Confianza: 2.19 %
4285 mm2
(x: 2.53, y: -0.39, z: 0.01)
Depósitos de óxido férrico débilmente adherido.
Incluído en discontinuidad final: 266641
IV-1B
ID: 246758

Confianza: 4.93 %
4680 mm2
(x: 2.53, y: -0.39, z: 0.01)
Rayaduras o zonas de metal expuestas con productos de óxido débilmente adherido.
Incluído en discontinuidad final: 266641
IV-1B
ID: 246763

Confianza: 70.65 %
5001 mm2
(x: 2.53, y: -0.41, z: 0.0)
Rayaduras o zonas de metal expuestas con productos de óxido débilmente adherido.
Incluído en discontinuidad final: 266641
IV-1B
ID: 246772

Confianza: 68.98 %
4659 mm2
(x: 2.53, y: -0.41, z: 0.01)
Rayaduras o zonas de metal expuestas con productos de óxido débilmente adherido.
Incluído en discontinuidad final: 266641
IV-4
ID: 246781

Confianza: 10.79 %
4067 mm2
(x: 2.53, y: -0.42, z: 0.01)
Depósitos de óxido férrico débilmente adherido.
Incluído en discontinuidad final: 266641
IV-1B
ID: 246782

Confianza: 10.31 %
4109 mm2
(x: 2.53, y: -0.42, z: 0.01)
Rayaduras o zonas de metal expuestas con productos de óxido débilmente adherido.
Incluído en discontinuidad final: 266641
IV-4
ID: 246788

Confianza: 29.33 %
3355 mm2
(x: 2.53, y: -0.42, z: 0.01)
Depósitos de óxido férrico débilmente adherido.
Incluído en discontinuidad final: 266641
Discontinuidad detectada
| Tipo |
IV-6
Residuos metálicos adheridos a la superficie, provenientes de operaciones adyacentes de fabricación y montaje. |
|---|---|
| Fecha | 26/06/2025 17:52 |
| Tamaño (mm) | 5001 mm2 |
| Tamaño (m) | 0.005 m2 |
| Confianza | 70.65 % |
| Posición |
X: 2.53 Y: -0.4 Z: 0.01 |
